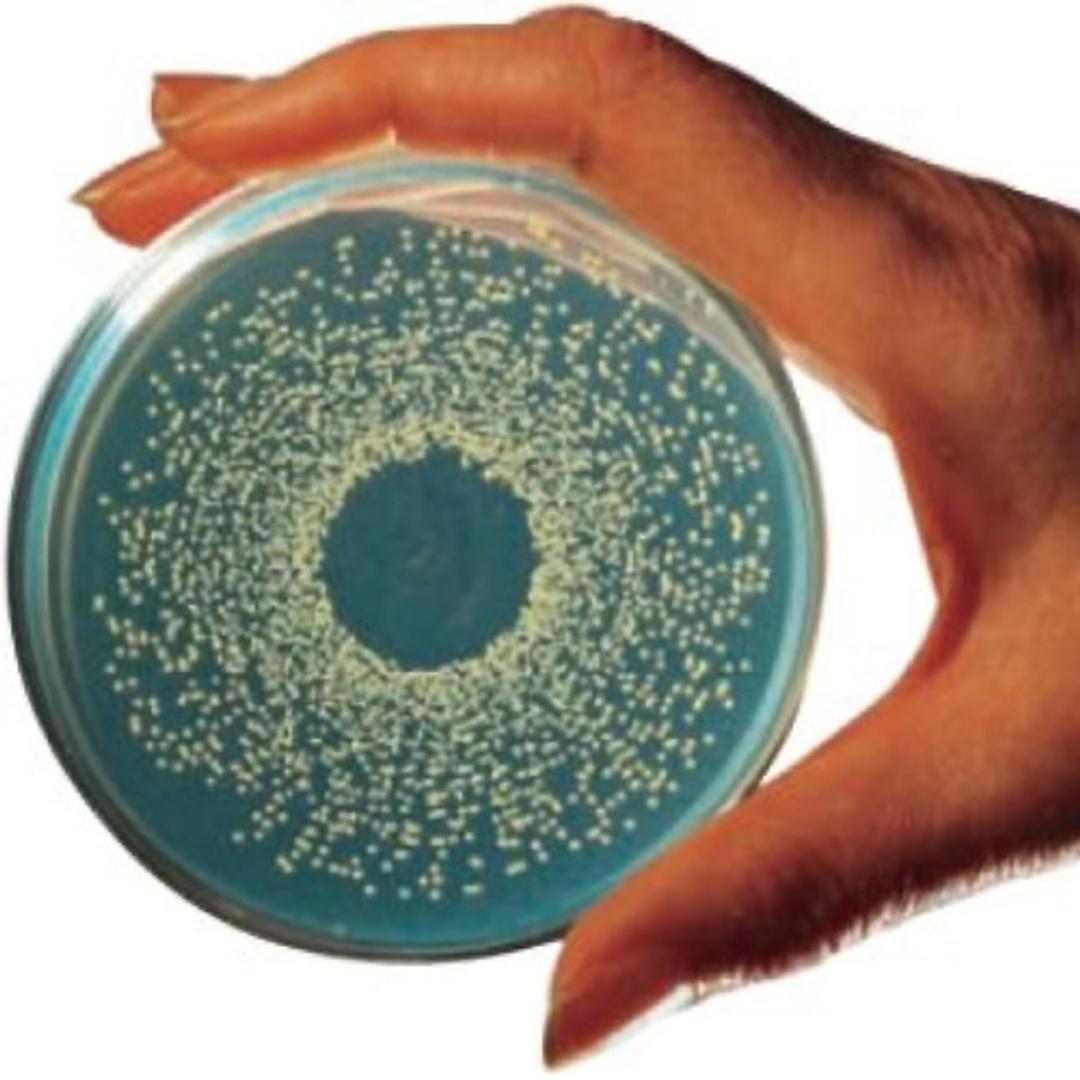

Whitley Automatic Spiral Plater
The WASP 2 spiral plate eliminates the need to produce dilution series for germ count determination. Spiral plates are not only used in food microbiology, but are also used in the pharmaceutical and cosmetics industries, for example for investigations of water, mouth, and skin bacteria.
It's a super helpful device that we don't want to miss anymore.
Microbiology - Preservation Load Test
The spiral board is a very effective device. It makes the work enormously easier when diluting samples, especially during the preservation load test and places the sample directly on the agar plate. The sample can be plated both logarithmically and linearly. In addition, there is the possibility to choose between 4 different volumes (50 μl, 100 μl, 200 μl, 400 μl). The device is very intuitive and minor faults can be fixed in the shortest possible time. However, it should be taken into account that the samples should be well soluble and not too firm + greasy, otherwise the hoses can quickly shut. In order to enjoy the device for a long time to come, we therefore no longer use W/O products.
Review Date: 15 Nov 2021
- Use without consumables for minimal operating costs
- With a single push of a button, the sample is loaded, a plate is inoculated, and the stylus is cleaned to optimize sample throughput speed
- It can deliver volumes from 10 μl to 400 μl and offers immense flexibility and repeatability
- 8 x 50 μl plates can be produced in syringe mode in 2 minutes and 35 seconds
- Optional 15 cm turntable for the use of 15 cm Petri dishes
- Optional self-centering, adjustable turntable - allows the use of 9 cm Petri dishes from different manufacturers without manual adjustment